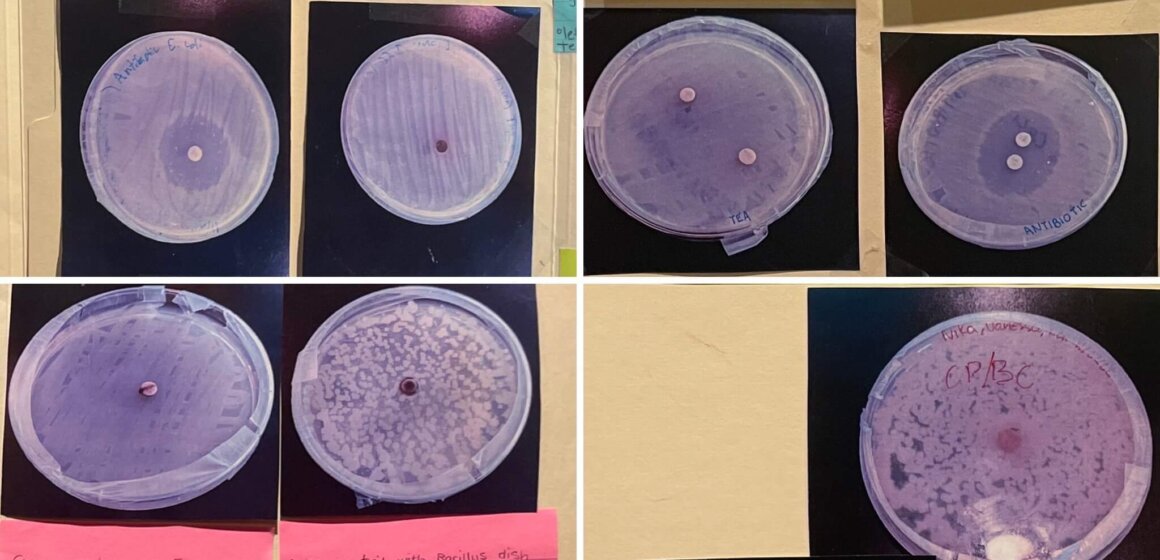
The biology students test whether or not common household ingredients offer natural antibacterial protection.

Carbonated Ice Cream
The Chemistry students discussed sublimation and triple point in a delicious way using carbon dioxide to make fizzy ice cream.

The Chemistry students discussed sublimation and triple point in a delicious way using carbon dioxide to make fizzy ice cream.

The Biology students tested whether or not common household ingredients offer natural antibacterial protection. None of the spices or herbs tested this year were promising. Maybe we’ll find one next year!

The Roanoke Field Studies students shared the “Not Wanted” posters they created about six invasive species of plants. Where did they come from, how did they get here, why are they an issue, and can we do anything about them? Brush up on your plant intelligence with these easy to read, informative summaries.

Roanoke Field Studies worked with students from Roanoke College to learn about the hydrology of the Roanoke River. They took measurements to calculate the river’s discharge rate, and tested pH, dissolved oxygen, and turbidity, and will compare their data to actual USGS water gage data in the classroom next week.
Visit our Science department page to learn more about how we incorporate laboratory and experiential work into our curriculum.

The Biology students had the pleasure of carrying out a favorite laboratory experiment – extracting DNA from strawberries.

The Physics class had the giant sling shot out again!
They first calculated the base velocity of the sling shot, and then used that data to determine which angle they needed to launch the ball to hit their target at varying distances. It was a perfect day for an outdoor experiment.

Astrobiology students studied the characteristics of life by trying to grow microbes from about a dozen different environments including pond water, yogurt, bread mold, and yeast. Dr. Ken Sosnowski, a retired microbiologist, came in to help the class identify what they grew.

The Roanoke Field Studies class visited Roanoke College’s new Environment Center on their most recent field trip. They are working with Dr. Rachel Collins in the Biology department to learn how to identify tree species using dichotomous keys. Students will return to the site in two weeks to collect data on 100 trees in a small wooded plot, then they will analyze their data back in the lab at CHS.

Students in Roanoke Field Studies took advantage of a beautiful day to work on the creation of materials and lesson plans to teach the concept of geologic time to younger students.
They made a rope timeline to symbolize the age of the earth, and plotted out when certain events occurred – such as the creation of the Appalachian Mountains, the first life on earth, the first humans, etc.